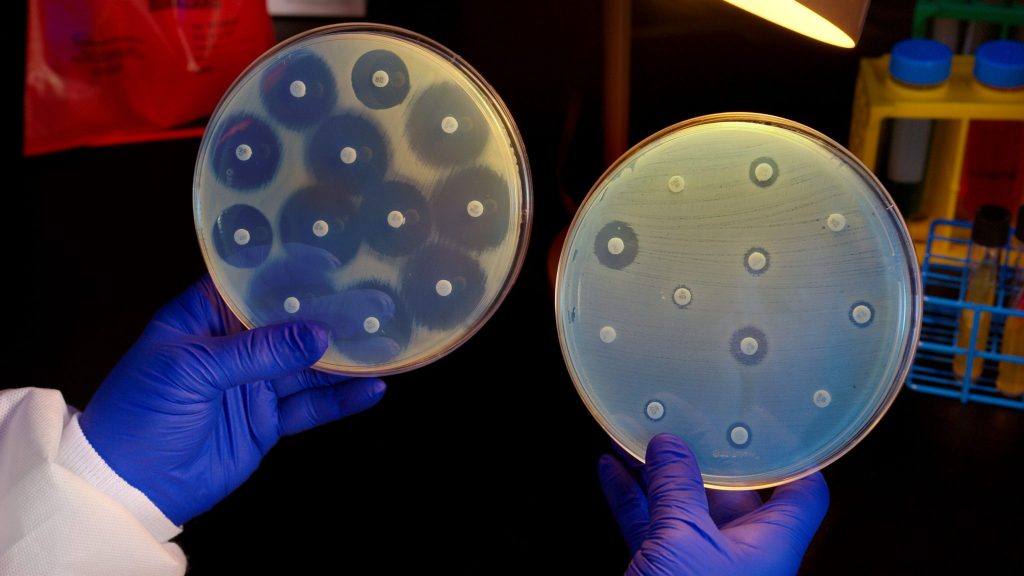

2025 jeep wrangler price one might not want to miss!...
September 25, 2025
4:48 am

explore surprisingly affordable luxury ram 1500...
September 25, 2025
4:34 am
What Is Nightmare Bacteria? Drug-Resistant Superbugs Rapidly Rising in the US
September 25, 2025
04:53
Cases of infections caused by so-called “nightmare bacteria”—pathogens resistant to nearly all available antibiotics, have surged nearly 70% between 2019 and 2023, according to a new report from the Centers for Disease Control and Prevention (CDC).
The findings, published Monday in the Annals of Internal Medicine, show that the sharp rise is largely linked to bacteria carrying the NDM gene (New Delhi metallo-β-lactamase), which makes infections exceptionally difficult to treat.
The term “nightmare bacteria” generally refers to a group of germs known as Carbapenem-resistant Enterobacteriaceae (CRE). This includes pathogens such as Escherichia coli (E. coli) and Klebsiella pneumoniae.
Recent Posts

want an suv with easy access and comfort for seniors? here’s how to get it!...
September 25, 2025
4:29 am

drive into the future with the 2025 subaru forester...
September 25, 2025
4:33 am

need a new car? rent to own cars no credit check ...
September 25, 2025
4:31 am

explore the 2025 jeep compas: adventure awaits!...
September 25, 2025
4:45 am
Initially, these infections were rare in the United States and often linked to patients who had received medical treatment abroad. But according to WION’s reporting, they are now increasingly appearing within U.S. hospitals and communities.
CDC scientists note several factors contributing to the surge in NDM-linked cases:
While the total number of cases remains relatively small, infections tied to the NDM gene have increased more than fivefold in recent years, according to U.S. News.
Recent Posts

celebrate the holidays in a new hyundai palisade...
September 25, 2025
4:49 am

2025 jeep wrangler price one might not want to miss!...
September 25, 2025
4:35 am

explore surprisingly affordable luxury ram 1500...
September 25, 2025
4:44 am

want an suv with easy access and comfort for seniors? here’s how to get it!...
September 25, 2025
4:46 am
Detecting CRE infections early is difficult because symptoms often resemble those of more common bacterial illnesses. Warning signs vary depending on the site of infection:
Because these symptoms overlap with other conditions, lab testing is essential for accurate diagnosis. Delayed detection can make effective treatment far more challenging.
Public health experts warn that the rise of CRE and the spread of the NDM gene marks a serious threat to modern medicine. With treatment options dwindling, everyday infections and routine surgeries could become much riskier.
Jennifer Ewbank, former CIA deputy director for digital innovation, told CNBC-TV18 that the rise of NDM-linked pathogens marks a “new chapter” in global antibiotic resistance—shifting from rare, overseas-linked cases to widespread domestic threats.
For U.S. health systems, the challenge lies not just in treating patients but also in preventing the bacteria from spreading further in hospitals and communities.
The surge of “nightmare bacteria” infections underscores the growing crisis of antibiotic resistance. With limited treatment options, prevention, early diagnosis, and strict infection-control measures are critical. Health officials say addressing the threat will require global cooperation, investment in new antibiotics, and public awareness.
Recent Posts

The arrest of Matthew Aaron VanDyke at Kolkata airport has drawn attention far beyond India’s borders. Authorities allege he entered the country on a tourist visa, travelled to the Northeast without permits, and attempted to...
March 21, 2026
7:17 am

drive into the future with the 2025 subaru forester...
March 21, 2026
6:53 am

A claim by U.S. Defense Secretary Pete Hegseth that grieving military families urged him to “finish the job” in Iran is facing scrutiny after at least one family member publicly disputed the account. The moment...
March 21, 2026
7:02 am

need a new car? rent to own cars no credit check ...
March 21, 2026
6:51 am

Norway’s Crown Princess Mette-Marit has publicly addressed her past association with convicted sex offender Jeffrey Epstein for the first time, describing herself as “manipulated and deceived.” The emotional interview, aired on national television, was meant...
March 21, 2026
2:19 am

explore the 2025 jeep compas: adventure awaits!...
March 21, 2026
1:53 am

The question, “Is the US getting isolated?” has resurfaced after a series of developments tied to the ongoing West Asia conflict. A fresh signal came from Switzerland, which announced it would suspend military exports to...
March 21, 2026
2:13 am

celebrate the holidays in a new hyundai palisade...
March 21, 2026
1:53 am

Chuck Norris, the martial arts champion turned Hollywood action star whose larger-than-life persona became internet folklore, has died at the age of 86. His family confirmed he passed away on Thursday in what they described...
March 21, 2026
2:10 am

2025 jeep wrangler price one might not want to miss!...
March 21, 2026
2:03 am

More than a decade after its failed first attempt, Amazon is reportedly developing a new AI smartphone. The project, internally codenamed “Transformer,” signals a renewed push into hardware, but this time with artificial intelligence at...
March 21, 2026
2:07 am

explore surprisingly affordable luxury ram 1500...
March 21, 2026
1:52 am